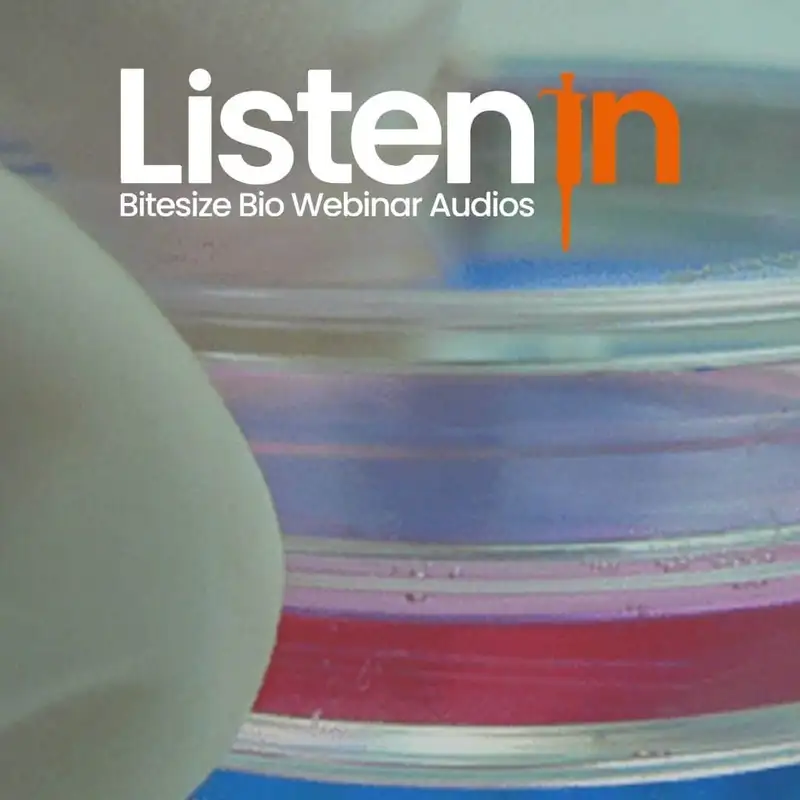
How to Ensure Your Cell-Based Assays Are Reproducible

How to Ensure Your Cell-Based Assays Are Reproducible
Join us in this webinar featuring Dr. Vicki Doronina as she takes you through vital components of assay design.
In this webinar, you will learn:
- How to choose between immortalized cells and primary cells for your assay
- How to avoid sources of bias in your cell-based assays
- How to use high throughput assays, so you can achieve greater reproducibility
By now, you have heard about the reproducibility crisis—the inability of scientists to reproduce experimental results. This crisis spurred journals to institute new requirements for publication and funding agencies to introduce more stringent rigor and reproducibility criteria. In this webinar, Vicki will address an often overlooked source of experimental variability: state of your cell lines and their external conditions.
The good news is that many of these factors can be addressed through assay design. She will show you how to move from poor reproducibility of so-called “artisan experiments” to the use of standard conditions for your cell lines and use of automatic systems for high throughput screens.